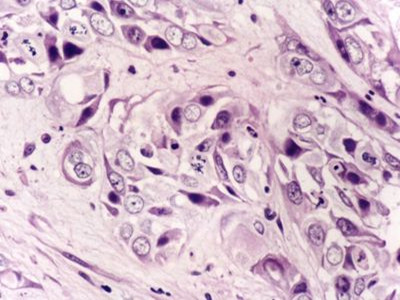

日期:04-26作者:科学减肥网
谈癌色变这是我们生活中的一种常见现象,归结起来就是癌症是我们目前一种不可治愈的难题。虽然说我们目前还没有确切的一种方法治疗癌症,但是我们可以通过一些有效的手段来预防癌症还是可以做到的。
癌症起源
细胞分裂或细胞增殖是普遍发生在许多组织的一个生理过程。通常细胞增殖和细胞凋亡会达到平衡,而且受到严谨地调控以保证器官和组织的完整性。DNA的突变或是经遗传得到的缺陷基因导致这些有序的过程受到改变。
随着细胞生长复制,如同滚雪球般持续累积新突变,最终不受管制而增殖的细胞通常会转变成良性肿瘤或恶性肿瘤。
良性肿瘤不会扩散到身体其他部份,或是侵入别的组织,除非压迫到重要的器官,否则也不会影响生命。恶性肿瘤则会侵略其他器官,转移到身体其他部位而危害生命。
有些并非发生在人类的癌症可能能经由传染而引起,例如发生于狗的史狄可氏肉瘤。有病患接受器官移植,由于移植器官中带有肿瘤,结果得到癌症。这是目前已知较类似经由传染而得的例子。